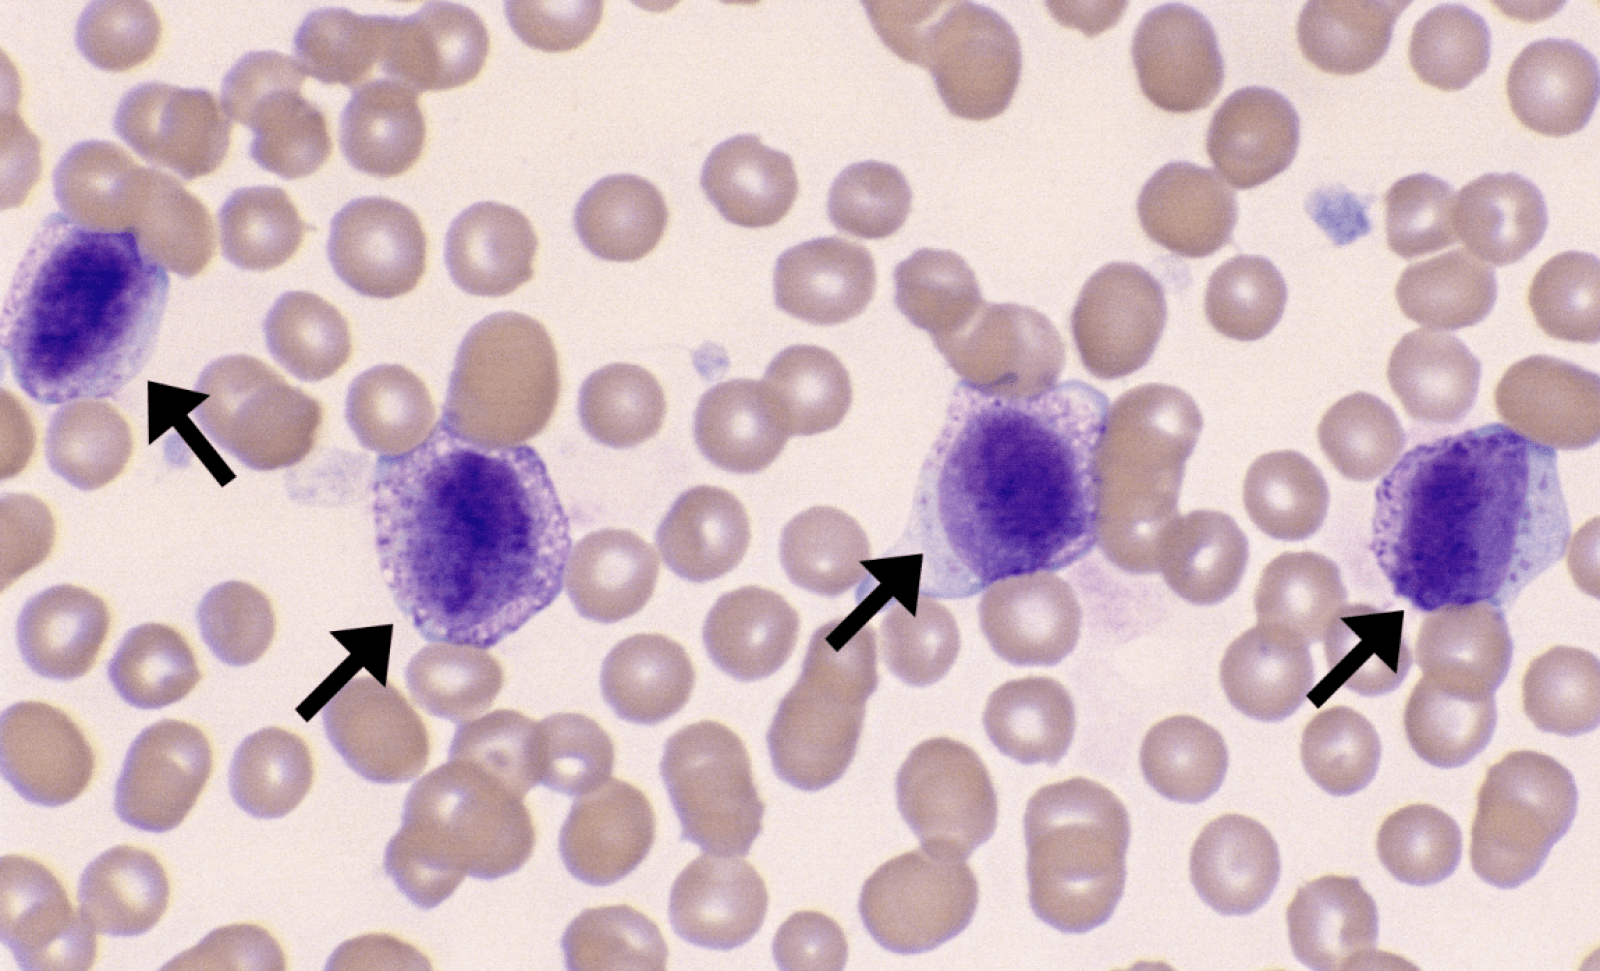

Alergie mogą mieć różny stopień nasilenia, od swędzących oczu i irytującego kataru po zagrażający życiu wstrząs anafilaktyczny. Orzeszki ziemne, kurz, pleśń, sierść kota, perfumy, pyłki, leki czy lateks – poza całkowitym unikaniem substancji uczulających, nie ma jednego stuprocentowo skutecznego sposobu, by chronić się przed reakcjami alergicznymi.
Czytaj też: Alergia na orzeszki ziemne w końcu pokonana? Takiego pomysłu jeszcze nie było
Wkrótce może się to zmienić dzięki uczonym z Northwestern University, którzy opracowali pierwszą selektywną terapię zapobiegającą reakcjom alergicznym. Jej podstawą są nanocząsteczki ozdobione przeciwciałami, które “wyłączają” nadaktywny układ odpornościowy. O postępach w tej dziedzinie można przeczytać w czasopiśmie Nature Nanotechnology.
Prof. Evan Scott z Northwestern University mówi:
Obecnie nie są dostępne żadne metody ukierunkowane konkretnie na komórki tuczne. Mamy tylko leki przeciwhistaminowe, które łagodzą objawy, a one nie zapobiegają alergiom. Przeciwdziałają działaniu histamin już po aktywacji komórek tucznych. Gdybyśmy mieli sposób na dezaktywację komórek tucznych, które reagują na określone alergeny, moglibyśmy zatrzymać niebezpieczne reakcje immunologiczne w poważnych sytuacjach, takich jak anafilaksja, a także mniej poważnych reakcjach, takich jak alergie sezonowe.
Każda alergia jest wywoływana przez komórki tuczne
Komórki tuczne, zwane także mastocytami, to komórki tkanki łącznej i błon śluzowych, mające okrągły lub owalny kształt. Powstają z prekursorów szpikowych, a do miejsca ostatecznego osiedlenia docierają niedojrzałe wraz z krwią. Dopiero w tkankach docelowych dojrzewają i przyjmują ostateczną postać. Pod względem wyglądu i funkcji są bardzo podobne do bazofili, innego rodzaju białych krwinek – kiedyś nawet je ze sobą mylono.
Czytaj też: Alergia na pyłki coraz groźniejsza. Jedna tabletka może nie wystarczyć
Komórki tuczne, zlokalizowane niemal we wszystkich tkankach ludzkiego ciała, są najbardziej znane z tego, że są odpowiedzialne za reakcje alergiczne. Ale odgrywają także kilka innych ważnych ról, w tym regulują przepływ krwi i zwalczają pasożyty, dlatego całkowite wyeliminowanie komórek tucznych w celu zapobiegania reakcjom alergicznym może być szkodliwe dla innych przydatnych reakcji.

Komórki tuczne alergika wychwytują przeciwciała, w szczególności immunoglobuliny typu E (IgE), przeciwko konkretnemu alergenowi (niemal zawsze jest to białko). Proces ten umożliwia komórkom tucznym rozpoznanie i reakcję na ten sam alergen, jeżeli dana osoba jest ponownie na niego narażona.
Prof. Bruce Bochner z Northwestern University wyjaśnia:
Obecnie nie ma leków zatwierdzonych przez FDA, które hamowałyby lub eliminowały komórki tuczne. Było to trudne głównie dlatego, że leki, które mogą wpływać na aktywację lub przeżycie komórek tucznych, celują również w komórki inne niż komórki tuczne, a zatem mają tendencję do wywoływania niepożądanych skutków ubocznych.
We wcześniejszych badaniach zidentyfikowano Siglec-6, unikalny receptor hamujący, który występuje w dużym stopniu na komórkach tucznych. Gdyby udało się skierować przeciwciało na ten receptor, można by selektywnie wyhamować komórki tuczne, aby zapobiec alergii. Do tej pory nie udało się uzyskać wystarczająco wysokiego stężenia przeciwciał, więc uczeni skierowali swój wzrok ku nanocząsteczkom.

Prof. Evan Scott dodaje:
Jeśli masz alergię na orzeszki ziemne, twoje komórki odpornościowe wytworzyły przeciwciała IgE przeciwko białkom orzeszków ziemnych, a komórki tuczne je przechwyciły. Teraz czekają, aż zjesz kolejny orzeszek ziemny. Kiedy to zrobisz, mogą zareagować w ciągu kilku minut, a jeśli reakcja jest wystarczająco silna, może to spowodować anafilaksję.
Alergia wcale nie musi nas męczyć
Aby białka (takie jak przeciwciała) przylgnęły do nanocząsteczki, zazwyczaj muszą utworzyć wiązanie chemiczne, które rozwinie (lub zdenaturuje) białko, wpływając na jego aktywność biologiczną. Aby ominąć to wyzwanie, prof. Scott wykorzystał nanocząsteczkę opracowaną wcześniej w swoim laboratorium. Składa się ona z dynamicznych łańcuchów polimerowych, które mogą niezależnie zmieniać swoją orientację pod wpływem różnych rozpuszczalników i białek. Po umieszczeniu w płynnych roztworach łańcuchy orientują się tak, aby uzyskać korzystne oddziaływania elektrostatyczne z cząsteczkami wody. Kiedy jednak białko dotyka powierzchni nanocząsteczki, specyficzne maleńkie łańcuchy polimerowe na granicy faz zmieniają swoją orientację, aby stabilnie trzymać się białka bez wiązania się z nim kowalencyjnie. Kluczem do stabilnej interakcji były wodoodporne kieszenie na powierzchniach białek.
Czytaj też: Alergia na kota pod kontrolą? Nigdy wcześniej tego nie próbowano
Aby selektywnie ukierunkować komórki tuczne, aby reagowały na konkretny alergen, naukowcy opracowali terapię tak, aby angażowała wyłącznie komórki tuczne niosące przeciwciała IgE przeciwko danemu alergenowi. Nanocząsteczka wykorzystuje alergen białkowy do interakcji z przeciwciałami IgE na komórkach tucznych, a następnie wykorzystuje przeciwciało do połączenia z receptorem Siglec-6 w celu wyłączenia zdolności komórek tucznych do reagowania. A ponieważ tylko komórki tuczne wykazują receptory Siglec-6, nanocząsteczka nie może wiązać się z innymi typami komórek – jest to strategia skutecznie ograniczająca skutki uboczne. Potwierdzono, że prawie 100 proc. przeciwciał anty-Siglec-6 przyczepiło się do nanocząsteczek, nie tracąc przy tym zdolności wiązania się z określonymi celami.
Naukowcy przetestowali terapię na modelach mysich. Ponieważ komórki tuczne tych gryzoni nie mają receptorów Siglec-6, opracowano model z ludzkimi komórkami tucznymi w ich tkankach. Zwierzęta poddano działaniu alergenu i jednocześnie podawano dożylnie nanocząsteczki – żadne nie doznało anafilaksji i wszystkie przeżyły.
Prof. Evan Scott podsumowuje:
Możesz użyć dowolnego alergenu, a selektywnie wyłączysz reakcję na ten alergen, który normalnie aktywowałby komórki tuczne. Ale w tym samym czasie, gdy alergen wiąże się, przeciwciało na nanocząsteczce angażuje się również w inhibitor receptora Siglec-6. Biorąc pod uwagę te dwa sprzeczne sygnały, komórka tuczna decyduje, że nie powinna się aktywować i powinna zostawić alergen w spokoju. Piękno tego podejścia polega na tym, że nie wymaga ono zabijania ani eliminowania wszystkich komórek tucznych.
Naukowcy planują zbadać zastosowaną nanoterapię w leczeniu innych chorób związanych z komórkami tucznymi, w tym mastocytozy, rzadkiej postaci raka komórek tucznych. Badają także metody ładowania leków do nanocząsteczek w celu selektywnego zabijania komórek tucznych w przypadku mastocytozy bez uszkadzania innych typów komórek.